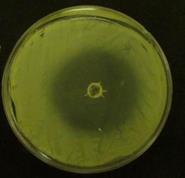

IN-VITRO ANTIBACTERIAL, ANTIFUNGAL, ANTIBIOFILM, AND ANTIOXIDANT POTENTIALS OF ISOPIMPINELLIN RECOVERED FROM CITRULLUS COLOCYNTHIS
MOHAMMED A. ALMALKI
Biological Sciences Department, College of Science, King Faisal University, Saudi Arabia
Email: almalkikfu@gmail.com
Received: 10 Jan 2016 Revised and Accepted: 11 Feb 2016
ABSTRACT
Objective: The novel molecules recovered from traditional medicinal plants have various biological applications with fewer side effects compared to the synthetic molecules. In this regards, the present study aimed to investigate the antibacterial, antifungal, anti-biofilm and antioxidant properties of novel metabolite isolated from the seeds of Citrullus colocynthis.
Methods: The ethyl acetate (EA) extract of C. colocynthis seed was mixed with a different proportion of hexane and Silica gel column packed for the collection of different fractions. The active fractions were checked for its purity by thin layer chromatography and HPLC. The identified single molecule was further characterized using IR, 1H NMR, 13C NMR and mass spectral analysis. The minimum inhibitory concentration (MIC) of the compound was determined using broth microdilution method. A fungal biomass inhibition effect, the anti-biofilm and anti-oxidant property of the compound was evaluated.
Results: Purification of theEA extract by Silica gel column guided to identify active antimicrobial metabolite containing fractions. Further separation technique and spectroscopic analysis lead to confirm the novel molecule isopimpinellin with the molecular formula C13H10O5. The identified metabolite revealed promising antimicrobial activity against Bacillus subtilis (100 µg/ml) and Klebsiella pneumoniae (75 µg/ml); whereas Aspergillus niger and Candida albicans documented the MIC values of 150 µg/ml and 75 µg/ml respectively. Fungal biomass inhibition effect study further proved the antifungal activity of the compounds against the filamentous fungal strains. In addition, the compound showed promising anti-biofilm activity against the uropathogenic strain such as Escherichia coli and Pseudomonas aeruginosa. Interestingly the antioxidant properties of the compound were an advantage. Both anti-biofilm and antioxidant activities were dose dependent.
Conclusion: Novel isopimpinellin with different biological activities such as antibacterial, antifungal, antibiofilm and antioxidant properties would be helpful in minimizing the spreading of pathogenic microorganisms or preventing stress-related diseases.
Keywords: Citrullus colocynthis, Isopimpinellin, Antibacterial, Antifungal, Antibiofilm, Antioxidant
© 2016 The Authors. Published by Innovare Academic Sciences Pvt Ltd. This is an open access article under the CC BY license (http://creativecommons.org/licenses/by/4.0/)
INTRODUCTION
From the past twenty years, many researchers are interested in the identification of novel bioactive metabolites with various biological activities. Many compounds derived from plants, bacteria, fungi and actinomycetes were known for its applications. Among that the novel unique molecules recovered from plants were highly attracted with researchers. Especially, the novel secondary metabolites derived from traditional medicinal plants have huge bioactivities such as anti-microbial, anti-cancer, antioxidant, antidiabetic and anti-inflammation. An additional factor for this renewed interest is the rapid rate of plant species extinction [1], which reduces the time left to explore the decreasing resources. Urgent efforts are necessary to collect and screen plants in order to determine if they should be conserved for the future beneficial use of humankind [2]. Medicinal plants are used by billions of people in most developing countries because of the frequently inadequate provision of modern medicine, their low cost, effectiveness, as well as cultural beliefs and preferences [3]. Treatment of infectious diseases resulted in the development of the excessive use of antibiotics which resulted in the antibiotics resistant microbial strains which increase the chance of treatment failure, thus necessitating the search for novel and potent therapeutic agents to treat bacterial and fungal infections [4-8]. Plants have wide amounts of metabolites that could be used to prevent microbial infections [9]. World Health Organization (WHO) estimates that more than 80 % of healthcare needs in developing countries are met through traditional health care practices.
Citrullus colocynthis is one of the famous medicinal plants commonly available in the dessert regions of Gulf countries. It is popularly known as bitter apple, bitter cucumber, colocynth, and desert gourd. It is a perennial plant and cultivated by both vegetative and generative methods. Also, the plant can be cultivated by using seed germinations. The roots, stems, leaves, flowers, fruits, and seeds are widely used as medicine and as energy sources (oilseed and biofuel). Reports claimed that the metabolites derived from C. colocynthis were used for the treatment of diabetes, diabetic neuropathy, and hyperlipidemia [10, 11]. Cucurbitacin glycosides recovered from C. colocynthis were used for the treatment of breast cancer [12]. The novel molecules isolated from this medicinal plant is used for the treatment of skin diseases, leprosy, sciatica, rheumatism, sprains, bruises, chronic rheumatism, cutaneous diseases, chronic bronchitis, chest infections, ophthalmic, and secondary syphilis. Besides that, it is used as a good stimulant for hair growth in mammals [13]. In addition, the secondary metabolites such as terpenoid, alkaloids, phenolic compounds and other functional group containing molecules were used in the treatment of infectious diseases caused by Staphylococcus aureus, Escherichia coli, Aspergillus flavus and Aspergillus fumigates [14]. The present study aimed to isolate novel molecule from this plant and investigates its antibacterial, antifungal properties. The novel molecule recovered from this medicinal plant exerted significant, antimicrobial, anti-biofilm and antioxidant activity; which give special attention to the pharmaceutical companies for the application of this molecules towards the treatment of degenerative disorders and cardiovascular diseases.
MATERIALS AND METHODS
Collection of plant materials and extraction
The seeds of C. colocynthis were collected from the Jazan Mountain (Al-Sarawat) of Saudi Arabia in March 2014. Jazan Region is the second smallest region of Saudi Arabia. It stretches some 300 km along the southern Red Sea coast, just north of Yemen. It covers an area of 11,671 km². The Al-Sarawat Mountains inland, which rise to about 3,000, meters This mountain region. The seeds were botanically confirmed and authenticated in the Department of Botany andMicrobiology, King Saud University, Riyadh,Saudi Arabia. The seeds were stored in the seed collection unit with the voucher CS-15-24. Approximately 500 gram of the seeds was washed thoroughly with common drinking water and air dried to remove the moisture content. Further, the seeds were kept for shade dry for 7 d. After that, the clean seeds were powdered in a mixer, and the fine powders were transferred into 2 l flask containing 1.5 l of ethyl acetate. The mixture was kept in orbital shaker for 48 h at room temperature with airtight cotton on the mouth part of the flask. After that, the debris free supernatant was separated by centrifugation at 10000 rpm for 20 min. The collected debris free supernatant was concentrated using vacuum evaporator at room temperature, and the crude extract was stored in the light resistant brown bottle for further laboratory usages.
Screening of the crude extract and identification of active molecules
The antibacterial and antifungal activity of the collected extract was investigated by disc diffusion method [15]. Since the extract exhibited comparatively better antimicrobial activity; it has been purified using column chromatography. Silica gel (Acme’s 100–200 mesh) was packed using hexane solvent, and the crude extract was mixed with silica gel with the ratio of 1:3 and carefully transferred on the top of the column. Later, the elution was carried out by using a different ratio of solvents such as hexane, ethyl acetate, and methanol. The collected fractions were pooled together based on their Rf values and the shortlist fractions (7 no) were vacuum evaporated. The concentrated fractions were further checked for their antimicrobial activity using disc diffusion method. The fraction 7 showed comparatively better activity was further purified using small level column packed with silica gel. After that, the packed fraction was carefully eluted by pouring different ratio of ethyl acetate and methanol. The collected fractions were pooled together based on their TLC profile and evaporated and checked for its antimicrobial activity. The TLC profile showing single spot was further studied for the chemical characterization. The functional group of the molecule was identified using Infrared spectroscopy (IR) by KBr pellet method. 1H NMR was run at either 300 or 400MHz and 13C NMR at 75 MHz using the solvent signal as a reference. The MASS spectrum of the molecules was determined using an electrospray ionization tandem mass spectrometry (ESI-MS/MS). The separation was carried out on an ODS-H column (100 × 2.1 mm i.d. 3.5 µm particle size; Shiseido, Tokyo, Japan) at a flow rate of 0.2 mL/min. The ion source was set to run in the negative ion mode (-3.5 kV) with N2 sheath gas at a nebulising pressure of 50 psi (344 kPa). The capillary temperature and voltage were set at 365oC and-15 V, respectively. The ion trap MS analysis was carried out with N2 as the collision gas, and the normalized collision energy was set to 30 %. The total ion chromatogram was obtained from 150 to 2000 m/z. The LC solvent system was delivered at a rate of 1.0 ml/min and consisted of a mixture of (A) 30 mM acetic acid: 0.07 % formic acid: methanol (85:5:10, v/v/v) and (B) 25 mM acetic acid: 0.05 % formic acid: methanol (72:5:23, v/v/v).
Antimicrobial activity
Tested microorganisms
The following bacteria and fungi were used for the experiment. Bacteria: Bacillus subtilis (ATCC 6059), Enterococcus faecalis (ATCC 29212), Staphylococcus aureus (ATCC 6538), Staphylococcus epidermidis (ATCC 1228), Escherichia coli (ATCC 11229), Klebsiella pneumoniae (ATCC 15380) and Pseudomonas aeruginosa (ATCC 27853); Fungi: Aspergillus flavus, Aspergillus niger, Alternaria alternata, Curvularia maculans, Curvularia lunata, Epidermophyton floccosum, Fusarium oxysporum, Penicillium citrinum, Botyritis cinerea and Candida albicans. The studied microbial pathogens were procured from American Type Culture Collection (ATCC).
Preparation of inoculums
Bacterial inoculums were prepared by growing cells in Mueller Hinton Broth (Himedia) for 24 h at 37 oC. These cell suspensions were diluted with sterile MHB to provide initial cell counts of about 104 CFU/ml. The filamentous fungi were grown on sabouraud dextrose agar (SDA) slants at 28 oC for 10 d and the spores were collected using sterile doubled distilled water and homogenized. Yeast was grown on sabouraud dextrose broth (SDB) at 28 oC for 48 h.
Minimum inhibitory concentration (MIC)
The minimum inhibitory concentration was performed according to the standard reference method [16]. The molecule was dissolved in water together with 2 % dimethyl sulfoxide (DMSO). The initial concentration of compound was 1 mg/ml. The initial test concentration was serially diluted twofold. Each well was inoculated with 5 µl of a suspension containing 108 CFU/ml of bacteria and 104 spores/ml of fungi, respectively. For fungi, the plates were incubated for 24, 48 or 72 h at 28 oC while bacteria plates were incubated for 24 h at 37 oC. MIC was defined as the lowest extract concentration, showing no visible fungal growth after incubation time. 5 µl of tested broth was placed on the sterile MHA plates for bacteria and incubated at respective temperature. The MIC for bacteria was determined as the lowest concentration of the compound inhibiting the visual growth of the test cultures on the agar plates.
Anti-biofilm activity
The anti biofilm activity was evaluated by following the method of Rejiniemon et al. [15]. E. coliand P. aeruginosa were cultivated in nutrient broth at 37 °C for 48 h under static condition. After that, the cultivated sterile tubes were washed thoroughly with sterile distilled water and stained with of 0.1 % (v/v) Crystal violet and Safranin for 10 min. The excess stain was removed by washing with sterile water. Tubes were then dried for overnight at 37 °C. Crystal violet-stained adherent S. aureus bacteria were re-dissolved in dimethyl sulphoxide (DMSO) whereas safranin-stained adherent P. aeruginosabacteria were re-dissolved in 30 % (v/v) glacial acetic acid. Thereafter, absorbance was recorded at 570 nm for crystal violet stained DMSO suspension and at 492 nm for Safranin stained glacial acetic acid suspension. Each test was performed in triplicate.
In vitro antioxidant activity
The antioxidant property of the isolated molecule was determined using DPPH method [17]. Briefly, freshly prepared DPPH solution in an ice cold methaol (0.15 %) was mixed with different concentrations of (10–50 µg/ml) of the compound under dark environment for 30 min, and the absorbance was read at 515 nm. The antioxidant activity was expressed as IC50 (µg/ml) (the antiradical dose required to cause a 50 % inhibition). Vitamin C was used as standard. The ability to scavenge the DPPH radical was calculated by the following formula:
Scavenging activity (%) = [1-(absorbance of sample-absorbance of blank)/absorbance of control] Χ 100
RESULTS
Citrullus colocynthis is commonly used in the treatment of various health related diseases and infectious disorders. In gulf region, this medicinal plant is very rarely studied for their bioactivities against various microbial pathogens. Therefore, the present study aimed to investigate the antibacterial, antifungal, anti biofilm and antioxidant properties of novel metabolite recovered from this medicinal plant. The seeds were collected from the gulf region were powdered and mixed with ethyl acetate solvent for the extraction. Initial antibacterial and antifungal studies of the extract revealed that the extract was prominent for further purification by collection of various fractions. Therefore, extract was packed in the column for further purification and the selected seven fractions were quickly screened against the selected microbial pathogens. The suspected fraction was checked for its purity in the thin layer chromatography and further confirmed by HPLC. The identified single molecule was further characterized for its chemical structure and molecular formula identification. The molecular weight of the compounds was determined using ESI-MS/MS. MS analysis indicated that the compound revealed major fragmentation at 245 (fig. 1). 1H NMR and 13C NMR chemical analysis exhibit the band and signal at 1.1, 1.5, and 2.9 (1H NMR) and 13C NMR showed the peaks and signals at 21.3, 28, 45, 56, 60.7, 99.8, 110.3, 115, and 125 respectively. The functional group of the metabolite study indicated the absorption maximum band at 910 and 812 places confirmed the presence of the hydroxyl double bond. Based on the above spectral results, it is predicted that the metabolite also containing phenolic groups, hydroxyl double bonds in their chemical structure. Further, the chemical structure of the compound was drawn as C13H10O5 and named as isopimpinellin (fig. 2).

Fig. 1: The Mass spectrum of the isolated compound isolated from C. colocynthis

Fig. 2: The chemical structure of the compound isolated from C. colocynthis
Antibacterial activity of the compound
The antibacterial potentials of the isolated compounds against the Gram-positive and Gram-negative microbial pathogens were investigated by measuring the minimum inhibitory concentrations by broth microdilution method. Among the Gram-positive bacteria, S. aureus exhibited the MIC of 50 ug/ml followed by B. subtilis and S. epidermidis (100 ug/ml). Whereas, E. faecalis revealed the highest MIC values (200 ug/ml) (fig. 3). In the case of Gram-negative bacteria, E. coli, K. pneumoniae and P. aeroginosa documented the MIC values of 50, 75 and 75 ug/ml respectively (table 1). The MIC values of the standard antibiotic were ranged from 2.5 to 50 ug/ml respectively for the tested microbial pathogens.
Fig. 3: In vitro antibacterial and antifungal activity of the compound against Staphylococcus epidermidis
Table 1: Minimum inhibitory concentration of the compound against Gram positive and Gram negative bacteria
Pathogenic strains |
Minimum inhibitory concentration (MIC) (µg/ml) |
|
Compound |
Streptomycin sulfate |
|
Gram-positive |
||
Bacillus subtilis (ATCC 6059) |
100 |
2.5 |
Staphylococcus aureus (ATCC 6538) |
50 |
37.5 |
Staphylococcus epidermidis (ATCC 1228) |
100 |
10 |
Enterococcus faecalis (ATCC 29212) |
200 |
25 |
Gram-negative |
||
Escherichia coli (ATCC 11229) |
50 |
25 |
Klebsiella pneumoniae (ATCC 15380) |
75 |
25 |
Pseudomonas aeroginosa (ATCC 27853) |
75 |
50 |
ATCC, American type culture collection; Streptomycin, (standard antibacterial agents). The experiments were performed in three times for the confirmation of the results
Antifungal activity of the compound
Table 2 represented the MIC values of the isolated compounds towards fungal pathogens. Among the ten tested pathogens, F. oxysporum and C. albicans shared MIC values of 75 ug/ml and A. flavus, C. maculans, E. floccosum and P. citrinum displayed MIC values of 100 ug/ml respectively. A. alternate and B. cinerea documented the highest MIC values (200 ug/ml). C. lunata and A. niger shared MIC values of 125 and 150 ug/ml respectively.
Standard antifungal metabolite revealed MIC values ranging within 25–100 µg/ml, respectively.
Table 2: Minimum inhibitory concentration of the compound against fungi
Pathogenic strains |
Minimum inhibitory concentration (MIC) (µg mL-1) |
|
Compound |
Standard |
|
Aspergillus flavus |
100 |
50 |
Aspergillus niger |
150 |
25 |
Alternaria alternata |
200 |
50 |
Botyritis cinerea |
200 |
50 |
Candida albicans |
75 |
25 |
Curvularia maculans |
100 |
50 |
Curvularia lunata |
125 |
100 |
Epidermophyton floccosum |
100 |
50 |
Fusarium oxysporum |
75 |
25 |
Penicillium citrinum |
100 |
25 |
The MIC of the compound was determined by broth microdilution method. The experiments were performed in three times for the confirmation of the results.
Growth inhibition effect of the compound against fungal pathogens
The growth inhibition effects of the compounds against the fungal pathogen were tested by supplementing 100 mg of the compounds in 100 ml of SD broth. After incubating the flasks for three days at 30 °C, the dry weight measurement of the fungal cells confirmed that the compounds significantly inhibited the growth when compared to the dry cell weight of the control fungal pathogens. Through analysis of the results indicated that the compounds revealed 62.2 % of the growth of Penicillium citrinum, whereas, F. oxysporum, C. lunata, C. maculans and A. flavus shared 53.46, 55.30, 52.63, 54.34 and 55.33 % of the growth inhibition (fig. 4). Among the fungi, E. floccosum, documented 43 % of biomass inhibition effect when the compound supplemented with the cultivation medium.

Fig. 4: Fungal biomass inhibition effect of the compound determined by dry cell weight
Anti-biofilm property of the compound
In vitro anti-biofilm property of the isolated compound was showed in fig. 5. The anti-biofilm of the compounds against E. coli and P. aeruginosa indicated that the activity was concentration dependent. The highest property was achieved in P. aeruginosa at 100 ug/ml, and the novel compound showed activity against all the tested concentration in the case of E. coli.

Fig. 5: In-vitro anti-biofilm activity of the compound isolated from C. colocynthis
Antioxidant activity of the compound
In vitro antioxidant activity of the isolated compound was determined by measuring the DPPH scavenging assays. Results indicated that the antioxidant potentials of the compound were concentration dependent, and the results were directly proportional to the tested concentrations fig. 6. The results concluded that the isolated compound had the highest hydroxyl radical scavenging ability, with an inhibition rate of 83.5 % at 500 µg/ml concentration, whereas vitamin C exhibited 90 % at 100 µg/ml concentration levels.

Fig. 6: In-vitro antioxidant property of the compound isolated from C. colocynthis
DISCUSSION
It is understood that the importance of identification of novel molecules from traditionally used medicinal plants for the treatment of various biological disorders in humans have higher advantages over the synthetic molecules because of the tremendous disadvantages such as side effects, creates allergic reactions, immune suppression, hypersensitivity, and the generation of multiple drugs resistant microbial strains. Therefore, it would be better if the researchers and scientist concentrate deeply in the field of traditional medicinal plants for the identification of novel bioactive molecules for various diseases [18]. The application of medicinal plants for the treatment of various disorders have been used for many years, and modern world populations still depend on the usage of traditional medicinal plants. The identified molecules from medicinal plants were the active ingredients in commonly used antibiotics [19]. Medicinal plants available in the man free environment is the ideal place for the discovery of novel molecules with various biological activities such as antibacterial, anticancer, antifungal, antidiarrheal, analgesics, antidiabetic, anti-inflammatory and antioxidant agents as well as various therapeutic potentials [20]. The importance’s of medicinal plants in Gulf region are widely studied by few researchers. However, the in-depth identification and characterization of important medicinal plants were very rarely studied. Citrullus colocynthis is one among the medicinal plant. Citrullus colocynthis is used for the treatment of various diseases such as cancer and skin infections. However, the importance of towards the inhibition of microbial pathogens such as bacteria and filamentous fungi were rarely studied. Therefore, the organic extracts of this plant seeds were studied for its antimicrobial activity. Initial screening revealed promising activity against the tested microbial pathogens. Further, the purification studies and chemical characterization of the selected fraction confirmed as isopimpinellin.
Antibacterial and antifungal potentials of the identified compounds were determined by evaluating its minimum inhibitory concentration. The results indicated that the identified molecules showed active in Gram-positive than the Gram-negative bacteria. The MIC values of the compound towards E. coli are interesting because it release various toxins like compounds in the intestine and affect the intestinal wall [21]. The MIC values were ranged from 50-200 ug/ml for both bacterial and fungal pathogens. Also, the results obtained in the present study were very significant. Interestingly the activities of the identified molecules towards the fungal pathogens were highly attractive, because, among the studied fungal strains, Aspergillus species were the causative agents for the cirrhosis of the liver. Gurudeeban et al. (2010) reported that the antimicrobial properties of C. colocynthis due to the presence of phtochemicals such as saponins, alkaloids, cardiac glycosides, steroids and tannins [22]. The identified novel compounds exerted remarkable fungal biomass inhibition against the pathogenic filamentous fungi. The complete or partial suppression of the growth of the fungal species in the liquid culture medium is an advantage of these isolated compounds. The results obtained were coincides with the recent report oAl-Dhabi et al. (2015), where the novel iso steviol recovered from endangered medicinal plant Pittosporum revealed fungal biomass inhibition against the filamentous fungi such as F. oxysporum, P. chrysogenum, B. cinerea, A. oryzae, A. clavatus and E. floccosum respectively [24].
Interestingly, the identified compound excels antibiofilm activity against the pathogens such as E. coli and P. aeroginosa. It is predicted that the compound might have interacted with E. coli and P. aeroginosa by preventing their attachment on the surfaces and the epithelial mucosa [23]. Among the tested pathogenic strains, P. aeruginosa is the most dangerous Gram-negative strain with high resistance to commonly used antibiotics [25]. The results of this study evidenced that the active compounds might have created the negative environmental conditions to the microbes by attaching on the surfaces; this is because the compounds might have a direct effect on the extracellular membranes of the strains which contain lipopolysaccharides and fimbriae [26].
In addition, the identified compound exhibited significant antioxidant activities. Even though the antioxidant activities were does dependent, at higher concentration, the compound comparatively revealed similar activity to the standard compound. Kamlesh et al. (2007) claimed that the microbial infections caused by the pathogenic strains create the environment for the generation of reactive molecules from oxygen which cause severe damage to the cells [27]. Matsui et al. (2007) reported that the presence of free radicals in the human body creates unfavorable conditions for membrane fluidity and enzyme receptor further causes diseases related to like diabetes, rheumatoid arthritis, cancer, aging, cardiovascular disease and epilepsy [28]. Traditional plant molecules contain phenolic functional groups in their structure have been proved for antioxidant activity [29]. Similar to the other plant molecule, the identified novel compound documented significant antioxidant activity [30].
CONCLUSION
In summary, we have described the antibacterial, antifungal, antibiofilm and antioxidant properties of the novel compound identified from Citrullus colocynthi. The MIC values of the compound against the studied pathogens were ranged from 75-200 ug/ml respectively. Among the bacterial strains, Gram-positive bacteria were more prominent in their activity, and filamentous fungal strains also showed good activity. Fungal biomass inhibition studies proved that the identified compounds have real activity. Besides the antimicrobial activities, the compound exhibited anti-biofilm activity against E. coli and P. aeroginosa. Interestingly, the identified compound documented good antioxidant activity; therefore, this compound could also be useful for the treatment of degenerative disorders and cardiovascular diseases. Identification, characterization and biological importance of the metabolite isolated from these medicinal plants give further attraction to the researcher working in the field of natural products.
CONFLICT INTERESTS
Declared none
REFERENCES
- Cowan MM. Plant products as antimicrobial agents. Clin Microbiol Rev 1999;12:564–2.
- Baker JT, Borris RP, Carte B, Cardell GA, Soejarto DD, Cragg GM, et al. Natural product drug discovery and development: new perspectives on international collaboration. J Nat Prod 1995;58:1325–7.
- Shanley P, Luz L. The impacts of forest degradation on medicinal plant use and implications for health care in Eastern Amazonia. BioScience2003;53:573–4.
- Bolivara P, Paredesa CC, Hernándezb LR, Juárezc ZN, Sánchez-Arreolab E, Av-Gaya Y, et al. Antimicrobial, anti-inflammatory, antiparasitic and cytotoxic activities of Galium mexicanum. J Ethnopharmacol 2011;137:141–7.
- Balamurugan R. Smilax chinensis Linn. (Liliaceae) root attenuates insulin resistance and ameliorates obesity in high diet induced obese rat. Int J Biol Sci 2015;1:47-1.
- Antonisamy P, Duraipandiyan V, Ignacimuthu S, Kim JH. Anti-diarrhoeal activity of friedelin isolated from Azima tetracantha Lam. in Wistar rats. South Indian J Biol Sci 2015;1:34-7
- MA Rathi, P Meenakshi, VK Gopalakrishnan. Hepatoprotective activity of ethanolic extract of Alysicarpus vaginalis against nitrobenzene-induced hepatic damage in rats. South Indian J Biol Sci 2015;1:60-5.
- Nandhini VS, Viji Stella Bai G. In-vitro phytopharmacological effect and cardio protective activity of Rauvolfia tetraphylla L. South Indian J Biol Sci 2015;1:97-2.
- Kuete V, Fozing DC, Kapche WFGD, Mbaveng AT, Kuiate JR, Ngadjui BT, et al. Antimicrobial activity of the methanolic extract and compounds from Morus mesozygia stem bark. J Ethnopharmacol 2009;124:551–5.
- Huseini HF, Darvishzadeh F, Heshmat R, Jafariazar Z, Raza M, Larijani B. The clinical investigation of I (L.) schrad fruit in the treatment of Type II diabetic patients: a randomized, double-blind, placebo-controlled clinical trial. Phytother Res 2009;23:1186–9.
- Rahbar AR, Nabipour I. The hypolipidemic effect of Citrullus colocynthis on patients with hyperlipidemia. Pak J Biol Sci 2010;13:1202–7.
- Tannin-Spitz T, Grossman SD, Sara GHE, Bergman M. Growth inhibitory activity of cucurbitacin glucosides isolated from Citrullus colocynthis on human breast cancer cells. Biochem Pharmacol 2007;73:56–7.
- Patel DK, Prasad SK, Kumar R, Hemalatha S. An overview on antidiabetic medicinal plants having insulin mimetic property. Asian Pac J Trop Biomed 2012;2:320–30.
- Gurudeeban S, Satyavani K, Ramanathan T. Bitter apple (Citrullus colocynthis): an overview of chemical composition and biomedical potentials. Asian J Plant Sci 2010;9:394–401.
- Rejiniemon TS, Arasu MV, Duraipandiyan V. In-vitro antimicrobial, antibiofilm, cytotoxic, antifeedant and larvicidal properties of novel quinone isolated from Aegle marmelos (Linn.) Correa. Ann Clin Microbiol Antimicrob 2014;13:48.
- Balachandran C, Duraipandiyan V, Emi N, Ignacimuthu S. Antimicrobial and cytotoxic properties of Streptomyces sp. (ERINLG-51) isolated from Southern Western Ghats. South Indian J Biol Sci 2015;1:7-4.
- Hatano T, Kagawa H, Yasuhara T, Okuda T. Two new flavonoids and other constituents in licorice root: their relative astringency and radical scavenging effects. Chem Pharm Bull 1988;36:2090–7.
- Zhang XB, Zou CL, Duan YX, Wu F, Li G. Activity-guided isolation and modification of juglone from Juglans regia as a potent cytotoxic agent against lung cancer cell lines. BMC Complementary Altern Med 2015;15:396.
- Bibi Y, Nisa S, Waheed A, Zia M, Sarwar S, Ahmed S, et al. Evaluation of Viburnum foetens for anticancer and antibacterial potential and phytochemical analysis. Afr J Biotechnol 2010;9:5611-5.>
- Hoareau L, DaSilva EJ. Medicinal plants: a re-emerging health aid. Electron J Biotechnol 1999;2:56–70.
- Gurudeeban S, Ramanathan T, Satyavani K, Dhinesh T. Antimicrobial effect of coastal medicinal plant–Citrullus colocynthis against pathogenic microorganisms. Afr J Pure Appl Chem 2011;5:119-2.
- Gurudeeban S, Ramanathan T. Antidiabetic activity of Citrullus colocynthis on alloxan induced albino rats. Ethnopharmacol 2010;1:1-5.
- Sun D, Courtney HS, Beachey EH. Berberine sulphate blocks adherence of Streptococcus pyogenes to epithelial cells, fibronectin, and hexadecane. Antimicrob Agents Chemother 1988;32:1370–4.
- Al-Dhabi NA, Arasu MV, Rejiniemon TS. In vitro antibacterial, antifungal, antibiofilm, antioxidant, and anticancer properties of iso steviol isolated from endangered medicinal plant Pittosporum tetraspermum. J Evidence-Based Complementary Altern Med 2015. Doi.org/10.1155/2015/164261. [Article in Press].
- Savafi L, Duran N, Savafi N, Onlem Y, Ocak S. The prevalence and resistance patterns of Pseudomans aeruginosa in intensive care units in a university Hospital. J Med Sci 2005;35:317.
- Sharon N, Ofek I. Safe as mother’s milk: carbohydrates as future anti-adhesion drugs for bacterial diseases. Glycocon J 2002;17:659–4.
- Kamlesh D, Yogesh S, Ajit P. Evaluation of in vitro antioxidant activity of Sida rhombifolia (L.) Ssp. Retusa (L.). J Med Food 2007;10:683–8.
- Matsui Y, Takagi H, Qu X, Abdellatif M, Sakoda H, Asano T, et al. Distinct roles of autophagy in the heart during ischemia and reperfusion: roles of AMP-activated protein kinase and Beclin 1 in mediating autophagy. Circ Res 2007;100:914–2.
- Evans RCA, Miller NJ, Paganga G. Antioxidant properties of phenolic compounds. Trends Plant Sci 1997;2:152.
- Anagnostopoulou MA, Kefalas P, Papageorgiou VP, Assimopoulou AN, Boskou D. Radical scavenging activity of various extracts and fractions of sweet orange peel (Citrus sinensis). Food Chem 2006;94:19–5.